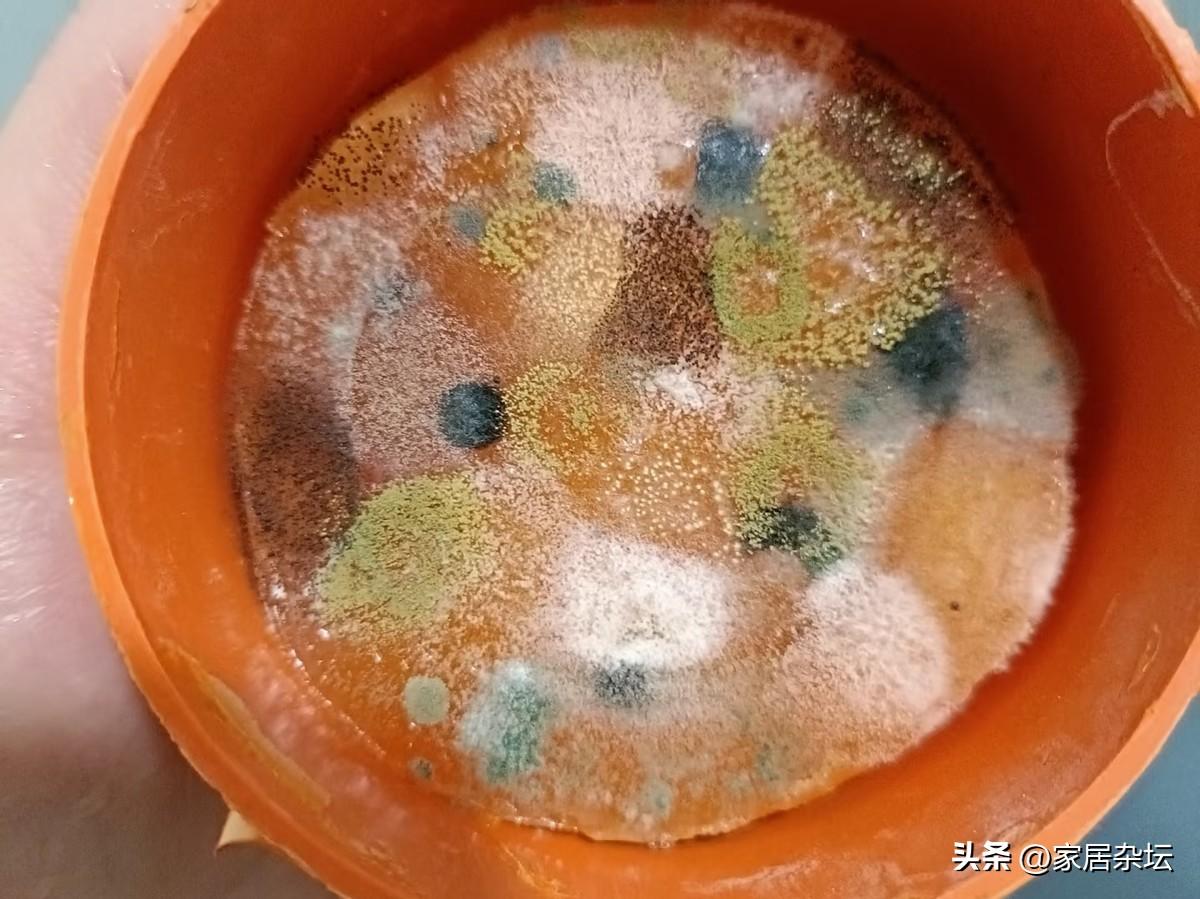

6大“致命廉價家居用品”,正在偷走你的健康,便宜也不能買
居家過日子,很多人都喜歡物美價廉的產品,尤其是家居用品方面,能省就省。
但是,有些廉價品背後,帶來的代價是損害健康。而且,可能遠遠超乎你的想象。
你知道有哪些致命廉價家居用品嗎?


本期分享:有害健康的廉價的家居用品。全文分成六部分:超低價牀墊;劣質空氣清新劑;廉價塑料食品容器;有刺激氣味的窗簾;合成地毯;廉價不粘鍋。


01 超低價牀墊
牀墊價格還是很貴的,動輒幾千甚至上萬。但是,也有一些超低價的牀墊,卻往往成爲了健康的隱形殺手,成爲了慢性疼痛的溫牀。


有一些百元左右的廉價牀墊,通常使用的是劣質的海綿,還有一些甲醛超標了的粘結劑。這些材料會釋放有害氣體,還沒有相應的支撐力,導致睡眠時脊柱處於不正常彎曲狀態。
睡時間長了,你會發現睡完覺腰痠背痛,還出現頸椎問題,越睡越累。
選購建議:
牀墊儘量選擇知名品牌,可以選擇入門級,確保環保標準。其實大家可以考慮天然乳膠或高品質的記憶牀墊。當然了,購買前要查看甲醛檢測報告。

02 劣質空氣清新劑
很多人習慣在家裏放空氣清新劑,特別是衛生間有異味,就放空氣清新劑。
但是,劣質的空氣清新劑千萬別用,否則卻成爲了呼吸道的隱形殺手。

許多廉價的空氣清新劑中,含有鄰苯二甲酸酯,有甲醛、苯類物質。這些化學物質,會通過呼吸道進入人體,影響內分泌系統,甚至還能增加哮喘和過敏的風險。
更爲可怕的是,這些空氣清新劑只是通過強烈香味掩蓋異味,並非是真正的能淨化空氣。
選購建議:
家用空氣清新劑儘量選擇天然精油,例如檸檬薰衣草精油。另外,要學會定期開窗通風,保持空氣流通。其實,也可以試試自制小蘇打加檸檬汁的天然清新劑。

03 廉價塑料食品容器
有很多的塑料製品進入我們的生活,有塑料碗,塑料飯盒,塑料筷子等等。
可是,有一些廉價的塑料食品容器千萬不要用,往往會成爲內分泌的干擾源。


廉價塑料食品容器,通常使用了不合格的塑料原料,其中有可能含有雙酚A(BPA)和塑化劑。這類材料遇到了高溫,或者是微波加熱,有害物質就會滲入到食物,從而被我們攝入體內,會干擾人體激素平衡。最終會帶來生殖系統疾病和患癌症的風險。
選購建議:
家用的食品容器儘量選擇玻璃或者是陶瓷的。如果是塑料的,一定要選擇標註BPA FREE的高品質塑料製品。其實,不鏽鋼的也是非常安全耐用的。

04 有刺激氣味的窗簾
不知道大家有沒有發現:現在買的布藝窗簾,剛裝上的時候,往往有很多有過刺激性的氣味。
這類窗簾奉勸大家不要買,因爲它們往往成爲揮發性有機化合物的來源。


新窗簾刺激性氣味,通常來自於甲醛和揮發性的有機化合物。而這些物質在紡織品的染色和防皺處理中,被廣泛應用。
可是,釋放的甲醛和揮發性有機化合物,往往會持續釋放數年。長期接觸會導致眼睛刺痛、呼吸道問題,甚至帶來免疫力的下降。
選購建議:
窗簾還是建議大家選擇天然纖維,例如棉、麻、絲材質。購買前一定要聞一聞,如果有明顯異味,千萬不要買。而且,新窗簾一定要清洗晾曬後使用。還有一點,儘量選淺色窗簾。

05 合成地毯
現在家庭裝修鋪地毯的越來越多,從客廳到廚房臥室,都出現了地毯。
但是,有一種地毯也就是合成地毯,儘量不要買,往往會成爲過敏原的聚集地。


由於廉價合成地毯通常使用了劣質的膠粘劑,結果就是可能會出現甲醛的釋放量超標。
同時,地毯纖維也非常容易藏匿灰塵、毛絮、蟎蟲和黴菌,最終成爲過敏的溫牀。結果就是會引發過敏性鼻炎,哮喘等呼吸道的疾病。
選購建議:
地毯儘量選擇天然材質的棉麻地毯或者是羊絨地毯。而且,要考慮易於清潔,儘量選擇小面積地毯,還要定期使用高效吸塵器清潔。

06 廉價不粘鍋
家庭中使用的鍋,越來越多的傾向於不粘鍋。而且,不粘鍋,各種各樣,五花八門。
其中的一種就是廉價不粘鍋,奉勸大家千萬別買,往往成爲高溫下的毒氣釋放源頭。


廉價不粘鍋的特氟龍塗層質量是不太穩定的,在高溫下(超過260℃)往往會分解釋放全氟辛酸(PFOA)等有害氣體。而這些物質與甲狀腺疾病高膽固醇等有關。
而且,一些劣質塗層非常容易剝落,有可能隨着食物就進入到人體。
選購建議:
家用的鍋具儘量選擇鑄鐵鍋,熟鐵鍋或者是不鏽鋼鍋,耐用又安全。如果選不粘鍋,一定要選擇知名品牌,並且避免高溫空燒。此外,陶瓷塗層鍋也是不錯的替代品。


以上是本期的【家居】專題,感謝閱讀,分享給更多的人!更多專題,歡迎關注“家居雜壇”,下一期再見!【文字原創,圖片源自網絡,侵權聯繫即刪】#萬能生活指南#

















